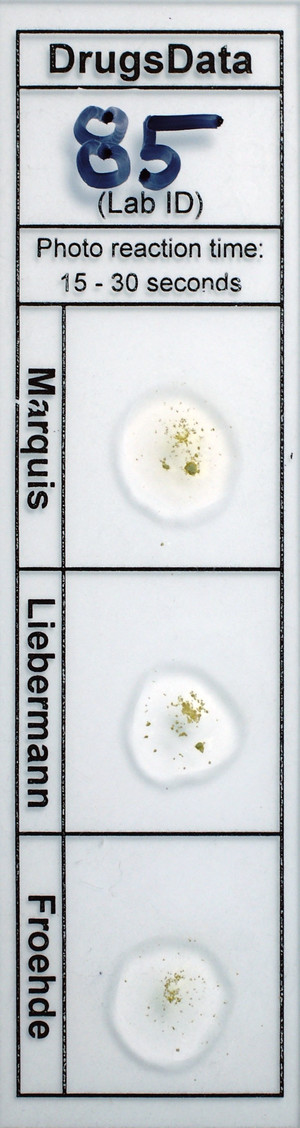

New Submissions Are Not Currently Being Accepted
Samples sent after April 10, 2024 will be put on hold.
Viewing desktop version: Switch to Mobile
Green Powder
Sold as: Xanax
ID: 14944
| ID: | 14944 |
|---|---|
| Name: | Green Powder |
| Other Names: | |
| UniqueCode: |
AC2022B0941A |
| Marquis: |
No Reaction |
| Liebermann | No Reaction |
| Froehde | No Reaction |
| GC/MS: |
|
Sold as: Xanax
Expected to be: Xanax
Has Been Tried: Yes
Description
Green powder from a green bar-style tablet (originally 2903?). [DrugsData accepts partial tablets and pulverized tablets by prior approval only.]